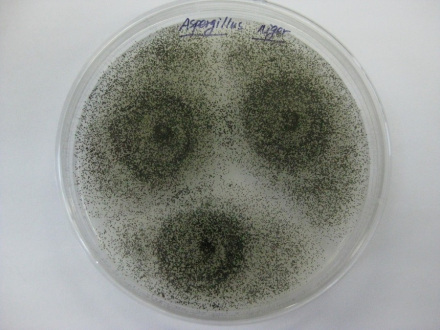
黑曲霉菌

-
黑曲霉菌 编辑
黑曲霉是半知菌亚门,丝孢纲,丝孢目,丛梗孢科,曲霉属中的一个常见种。黑曲霉生孢子梗自基质中伸出,直径15-20微米,长1-3毫米,壁厚而光滑。顶部形成球形顶囊,其上全面覆盖一层梗基和一层小梗,小梗上长有成串褐黑色的球状分生孢子。孢子直径2.5-4微米。分生孢子头球状,直径700-800微米,褐黑色。菌落蔓延迅速,初为白色,后变成鲜黄色直至黑色厚绒状。背面无色或中央略带黄褐色。有时在新分离的菌株中能找到白色、圆形、直径约l毫米的菌核。分生孢子头褐黑色放射状,分生孢子梗长短不一。顶囊球形,双层小梗。分生孢子褐色球形。
顶囊有单层和双层瓶梗,可与烟曲霉、灰绿曲霉、棒曲霉,以及土曲霉、杂色曲霉和构巢曲霉相鉴别。分生孢子梗光滑,无色至褐色,菌落初为白色,继而黑色,可与黄曲霉相鉴别。
黑曲霉广泛分布于世界各地的粮食、植物性产品和土壤中,是重要的发酵工业菌种,可生产淀粉酶、酸性蛋白酶、纤维素酶、果胶酶、葡萄糖氧化酶、柠檬酸、葡糖酸和没食子酸等。有的菌株还可将羟基孕甾酮转化为雄烯。生长适温为37℃左右,最低相对湿度为88%,能引起水分较高的粮食霉变和其他工业器材的霉变。
别名:烟灰曲霉、黑色曲霉、波黑曲霉、长担曲霉、鸟黑曲霉
界:真菌界
门:半知菌亚门
纲:丝孢纲
目:丝孢目
科:丛梗孢科
属:曲霉属
中文学名:黑曲霉
 黑曲霉菌
黑曲霉菌
(2)顶部形成球形顶囊,其上全面覆盖一层梗基和一层小梗,小梗上长有成串褐黑色的球状,直径2.5-4. 0μm。
(3)分生孢子头球状或呈放射状,形似菊花,直径700-800μm,褐黑色。蔓延迅速,初为白色,后变成鲜黄色直至黑色厚绒状,背面无色或中央略带黄褐色。
(4)分生孢子梗由特化了的厚壁而膨大的菌丝细胞(足细胞)上垂直生出,长短不一。
(5)黑曲霉的菌丝、孢子头常呈现各种颜色,如黑、棕、绿、黄、橙、褐等,菌种不同,颜色也不同。
培养物镜下可见菌丝体、分生孢子头和分生孢子,菌丝有隔膜、透明和内含颗粒,外壁粗糙。分生孢子头开始为球形,逐渐变为放射状,黑褐色;分生孢子梗长500-2500μm,径15-20μm,无色或上部为浅黄色,光滑。顶囊近球形,直径20-50μm,无色或黄褐色。双层小梗布满顶囊,呈褐色,梗基为(20-30)μmx(5-6)μm,长者可达60-70μm,宽8-10μm,呈放射状,有时有横隔。小分生孢子呈球形,直径4-5μm。由于褐色色素沉积在内壁和外壁呈棍状或块状,故整个孢子表面较粗糙有小刺。
 黑曲霉菌
黑曲霉菌
2.马铃薯葡萄糖琼脂上,菌落特点接近沙氏琼脂,菌落表面黑色颗粒较沙氏琼脂上菌落颗粒粗。
3.察氏琼脂上,生长迅速,质地丝绒状或稍呈絮状,少数菌株生长较局限。表面呈暗褐黑色至炭黑色,反面无色或淡黄色。察氏琼脂上菌落相比SDA和PDA,生长稍慢,菌落表面黑色颗粒稀疏。
在PDA培养基上菌落生长迅速,10-14日直径可达25-3cm,菌落初为白色,常有鲜黄色区域,厚绒状,继而黑色,背面无色或中央部分略带褐色。
黑曲霉菌
黑曲霉菌
(2)斜面培养基要求:可在麦芽汁4波美度左右培养。
(3)繁殖形式:黑曲霉以无性生殖的形式繁殖。
(4)最适温度:生长最适温度33-37℃,产酸最适温度28-37℃,温度过高易形成杂酸。
(5)最适pH:生长最适pH3-7,产酸最适pH1.8-2.5。
(6)有多种酶系具有多种活力较强的酶系。
(7)利用原料能利用淀粉类物质。
(8)分解能力对蛋白质、单宁、纤维素、果胶等具有一定分解能力。
(9)生成柠檬酸方式黑曲霉可以边长菌、边糖化、边发酵产酸的方式生成柠檬酸。
根据培养与镜检,菌落生长快,黑色或黑褐色,1-4d即可进行鉴定。顶囊球形或近球形,小梗双层、密生于顶囊全部表面。镜检注意与亮白曲霉进行区分,后者菌落颜色为白色,生长慢。幼龄时黄色菌落注意与黄曲霉相区分:前者菌落表面黄色颗粒稀疏、为淡黄色,后者黄色颗粒较粗、密,为金黄色,两者镜下差异显著。
分布于世界各地,在各种基质上普遍存在,为实验室常见污染菌。
 黑曲霉菌
黑曲霉菌
黑曲霉是免疫正常人耳真菌病中最常见分离菌,还可引起免疫低下患者深部真菌感染,可导致真菌性角膜炎等。
黑曲霉除能引起曲霉病外,也能产生黑曲霉毒素。
干酪成熟中污染会使干酪表面变黑、变质,对奶油也会产生变色。
黑曲霉菌可引起肺部感染。
1、本站所有文本、信息、视频文件等,仅代表本站观点或作者本人观点,请网友谨慎参考使用。
2、本站信息均为作者提供和网友推荐收集整理而来,仅供学习和研究使用。
3、对任何由于使用本站内容而引起的诉讼、纠纷,本站不承担任何责任。
4、如有侵犯你版权的,请来信(邮箱:baike52199@gmail.com)指出,核实后,本站将立即删除。






























